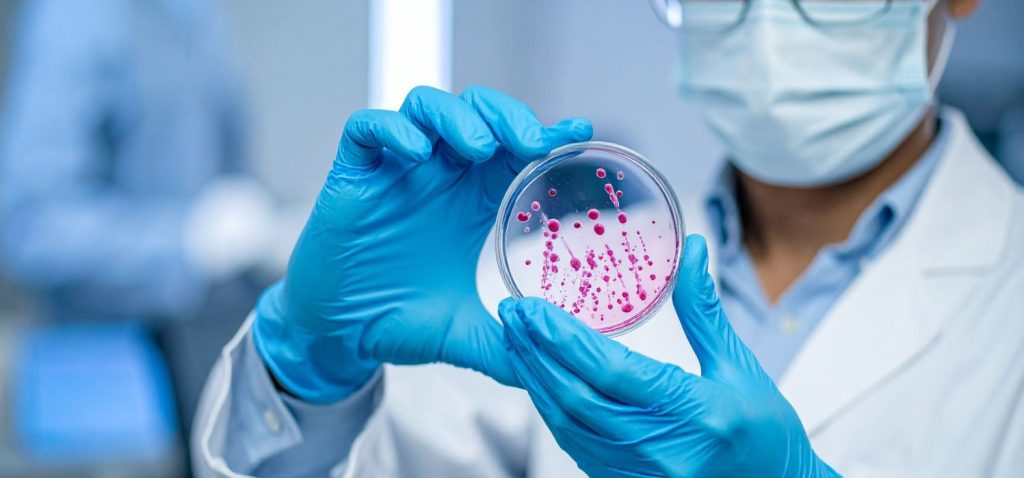
Borosilicate Petri Dishes

Every tool matters when you’re working in a lab. That’s why we offer high-quality borosilicate petri dishes made to meet your everyday lab needs. Whether you’re in education, research, or industrial testing, using the right petri dish can make your work easier and more reliable.
At Livingstone International, we supply durable, clear, and reusable petri dishes designed for repeat use. Our borosilicate petri dish stands out because of its excellent heat resistance and strong build. Let’s explore why our borosilicate glass petri dish is the ideal choice for your workspace.
What is a Borosilicate Petri Dish?
A borosilicate petri dish is a round, flat container made from borosilicate glass. This type of glass is known for its ability to handle high temperatures without breaking or warping. You can heat it directly without worrying about cracks. Unlike regular glass, borosilicate is more resistant to thermal shock.
This makes our borosilicate glass petri dish a competent and reliable choice in labs that deal with heat, steam, or repeated sterilisation. It gives you a clear view of your samples, resists damage, and lasts longer.
Heat Resistance That Works for You
Heat is a standard part of lab work. Whether you’re sterilising equipment, conducting heat-based experiments, or using an autoclave, your tools must handle the pressure. Our borosilicate petri dish is built for this.
It can handle temperatures well above 100°C, making it suitable for boiling, autoclaving, or dry heating. Even after multiple uses, you won’t need to worry about it cracking or warping. That kind of reliability saves you time and money.
When you choose our borosilicate glass lab dish, you’re choosing a product that performs under pressure and keeps your samples safe.
Easy Reuse, Less Waste
In a busy lab, saving on supplies without risking quality is key. Our borosilicate glass petri dish offers an eco-friendly and cost-effective solution. You can clean, sterilise, and reuse it many times without any drop in quality.
This makes it ideal for schools, universities, clinical labs, and research settings. You won’t have to keep buying disposable alternatives, which helps reduce lab waste and lowers operating costs over time.
If you’re looking for a product that balances performance and sustainability, our borosilicate petri dish is the answer.
Clarity and Stability You Can Trust
When working with cultures or samples, clarity matters. Our borosil glass lab dish provides a smooth, transparent surface so you can observe your samples without distortion. You get a clear view every time, which helps in accurate results.
The dish’s flat base stays firm on your workbench, so you won’t have to worry about tipping or sliding. Its firm edges and uniform thickness make it easy to handle, stack, and store safely.
Designed for Real Lab Use
Our borosilicate petri dishes come in practical sizes to suit everyday lab tasks. The popular 100mm x 20mm size offers the correct depth and surface area for culture growth and observation. Whether you work in microbiology, botany, or general lab experiments, this size works well for most tasks.
Each dish is made with precision and quality. When you use one of our dishes, you’re using labware designed to support your process, not slow it down.
Why Choose Our Borosilicate Glass Petri Dish?
We know lab work can’t wait. That’s why we keep quality and supply in mind. When you buy from us, you get:
- Premium-grade borosilicate glass
- High heat resistance
- Smooth and clear surface
- Durable and reusable quality
- Ideal for autoclaving
- Great value for money
Our petri dishes are packed carefully to avoid breakage and are ready to ship when you need them.
Who Should Use These Petri Dishes?
Our borosilicate petri dishes are ideal for:
- Schools and universities
- Research labs
- Food and water testing centres
- Microbiology and biotech labs
- Clinical and pathology settings
If your work involves heating, sterilising, or long-term sample observation, our borosilicate glass lab dish is a reliable option.
Order Your Lab Dishes with Confidence
You don’t need to spend extra for quality labware. Our borosilicate glass petri dish offers performance, durability, and value. Whether you need one or a whole batch, we’re here to help you stock up with ease.
Visit our product page today to view complete specs and place your order. We’re ready to supply what your lab needs, without delays or complications.
Conclusion
Our Livingstone International borosilicate petri dish is dependable, reusable, and durable. It’s the wise choice for any lab environment where quality and consistency are paramount. Order now and experience the difference in every dish.